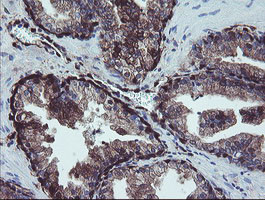
TSC22D1 Antibody in Immunohistochemistry (Paraffin) (IHC (P))

Search
OriGene
TSC22D1 Monoclonal Antibody (OTI1A5), TrueMAB™
{{$productOrderCtrl.translations['antibody.pdp.commerceCard.promotion.promotions']}}
{{$productOrderCtrl.translations['antibody.pdp.commerceCard.promotion.viewpromo']}}
{{$productOrderCtrl.translations['antibody.pdp.commerceCard.promotion.promocode']}}: {{promo.promoCode}} {{promo.promoTitle}} {{promo.promoDescription}}. {{$productOrderCtrl.translations['antibody.pdp.commerceCard.promotion.learnmore']}}
产品信息
CF505048
种属反应
宿主/亚型
分类
类型
克隆号
抗原
偶联物
形式
浓度
纯化类型
保存液
内含物
保存条件
运输条件
产品详细信息
For reconstitution, we recommend adding 100 µL distilled water to a final antibody concentration of about 1 mg/mL. To use this carrier-free antibody for conjugation experiments, we strongly recommend performing another round of desalting. (Zeba Spin Desalting Columns, 7KMWCO, 0.5 mL, Product # 89882)
靶标信息
TSC22 domain family protein, or TSC22, is a transcription factor that belongs to the large family of early response genes. This transcriptional repressor is known to act on the C-type natriuretic peptide (CNP) promoter. TSC22 belongs to the TSC-22/Dip/Bun family and is an intracellular protein that may be found in the cytoplasm or nucleus. This transcription factor is known to regulate cell growth, differentiation and cell death and is involved in modulating the transcriptional activity of Smad3 and Smad4. This protein is ubiquitously expressed in most tissues and widely in both fetal and adult tissues. It is generally expressed in aortic endothelial cells, and induced by cytokines, including TGFB. These proteins may be possible therapeutic targets of leukemia and prostate cancer.
仅用于科研。不用于诊断过程。未经明确授权不得转售。
篇参考文献 (0)
生物信息学
蛋白别名: Cerebral protein 2; HUCEP-2; Regulatory protein TSC-22; RP11-269C23.2; TGFB-stimulated clone 22 homolog; TGFbeta-stimulated clone 22; transcriptional regulator TSC-22; Transforming growth factor beta-1-induced transcript 4 protein; transforming growth factor beta-stimulated protein TSC-22; TSC22 domain family protein 1; TSC22 domain family, member 1
基因别名: hucep-2; KIAA1994; Ptg-2; TGFB1I4; TSC22; TSC22D1
UniProt ID: (Human) Q15714
Entrez Gene ID: (Human) 8848